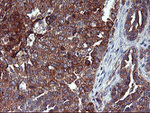
ENPEP Antibody in Immunohistochemistry (Paraffin) (IHC (P))

Search
OriGene
ENPEP Monoclonal Antibody (OTI1E3), TrueMAB™
{{$productOrderCtrl.translations['antibody.pdp.commerceCard.promotion.promotions']}}
{{$productOrderCtrl.translations['antibody.pdp.commerceCard.promotion.viewpromo']}}
{{$productOrderCtrl.translations['antibody.pdp.commerceCard.promotion.promocode']}}: {{promo.promoCode}} {{promo.promoTitle}} {{promo.promoDescription}}. {{$productOrderCtrl.translations['antibody.pdp.commerceCard.promotion.learnmore']}}
产品信息
CF504071
种属反应
宿主/亚型
分类
类型
克隆号
抗原
偶联物
形式
浓度
纯化类型
保存液
内含物
保存条件
运输条件
产品详细信息
For reconstitution, we recommend adding 100 µL distilled water to a final antibody concentration of about 1 mg/mL. To use this carrier-free antibody for conjugation experiments, we strongly recommend performing another round of desalting. (Zeba Spin Desalting Columns, 7KMWCO, 0.5 mL, Product # 89882)
靶标信息
CD249 appears to have a role in the catabolic pathway of the renin-angiotensin system. Probably plays a role in regulating growth and differentiation of early B-lineage cells.
仅用于科研。不用于诊断过程。未经明确授权不得转售。
篇参考文献 (0)
生物信息学
蛋白别名: Aminopeptidase A; AP-A; BP1; CD249; Differentiation antigen gp160; EAP; Glutamyl aminopeptidase; glutamyl aminopeptidase (aminopeptidase A)
基因别名: APA; CD249; ENPEP; gp160
UniProt ID: (Human) Q07075
Entrez Gene ID: (Human) 2028